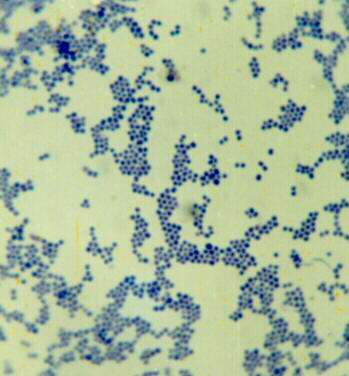
葡萄球菌

历史发展
葡萄球菌是柯赫(R.Koch.1878年)、巴斯德(L.Pasteur,1880年)和奥格斯顿(A.Og-ston,1881年)从脓液中发现的,但通过纯培养并进行详细研究的是F.J.Rosenbach(1884年)。从黄色葡萄球菌的细胞壁分离出的蛋白质A可与免疫球蛋白(主要为IgG)进行特异的结合,这是由K.Jensen氏(1959年)发现的,现已被应用于各种免疫反应。

病菌分类
葡萄球菌的代表种有金黄色葡萄球菌(S-taphylococcusaureus)(黄色)、白色葡萄球菌(S.albus)(白色)、柠檬色葡萄球菌(S.citreus)(橙色)等。S.aureus是各种脓疡(abscess)的病原菌,S.albus和S.citreus在人的健康体表上为半腐物营养型。由于在普通肉汁培养基中能很好地发育,所以培养比较简单,但刚从动物体上分离的,对各种氨基酸和生长因子的要求较高,特别是对烟酸、硫胺素的要求更为明显。在自然界已发现许多介于S.aureus与S.albus中间型的种类。
该细菌是抗菌物质中毒和一般营养不良时成为次级的微生物区系的主要细菌。因乳制品和肉类的腐败而出现的中毒,认为多由此类细菌引起,原因是葡萄球菌在增殖过程中可产生肠毒素(enterotoxin)。这种毒素的生物活性在于能刺激呕吐中枢产生催吐作用。然而与人皮肤脓疡类似的种类不易在动物体上发生,只有极少数的可在类人猿和兔发生类似的症状。
生物学性状
形态染色
球形或稍呈椭圆形,直径1.0um左右,排列成葡萄状。葡萄球菌无鞭毛,不能运动。无芽胞,除少数菌株外一般不形成荚膜。易被常用的碱性染料着色,革兰氏染色为阳性。其衰老、死亡或被白细胞吞噬后,以及耐药的某些菌株可被染成革兰氏阴性。
培养特性
营养要求不高,在普通培养基上生长良好,在含有血液和葡萄 糖的培养基中生长更佳,需氧或兼性厌氧,少数专性厌氧。28~38℃均能生长,致病菌最适温度为37℃,PH为4.5~9.8,最适为7.4。在肉汤培养基中24小时后呈均匀混浊生长,在琼脂平板上形成圆形凸起,边缘整齐,表面光滑,湿润,不透明的菌落。不同种的菌标产生不同的色素,如金黄色、白色、柠檬色。色素为脂溶性。葡萄球菌在血琼脂平板上形成的菌落较大,有的菌株菌落周围形成明显的完全透明溶血环(β溶血),也有不发生溶血者。凡溶血性菌株大多具有致病性。
生化反应
多数葡萄球菌能分解葡萄糖、麦芽糖和蔗糖,产酸不产生气。致病性菌株能分解甘露醇。
分类与分型
根据生化反应和 产生色素不同,可分为金黄色葡萄球菌(Staph.aureus)、表皮葡萄球菌(Staph. epidermidis)和腐生葡萄球菌(Staph.saprophytics)三种。其中金黄色葡萄球菌多为致病菌,表皮葡萄球菌偶尔致病,腐生葡萄球菌一般不致病。60%~70%的金黄色葡萄球菌可被相应噬菌体裂解,表皮葡萄球菌不敏感。用噬菌体可将金葡萄菌分为4群23个型。肠毒素型食物中毒由Ⅲ和Ⅳ群金葡萄菌引起,Ⅱ群菌对抗生素产生耐药性的速度比Ⅰ和Ⅳ群缓慢很多。造成医院感染严重流行的是Ⅰ群中的52、52A、80和81型菌株。引起疱疹性和剥脱性皮炎的菌株经常是Ⅱ群71型。

抗原结构
葡萄球菌抗原构造复杂,已发现的在30种以上,其化学组成及生 物学活性了解的仅少数几种。

1.葡萄球菌A蛋白(Staphylococcal protein A,SPA)存在于菌细胞壁的一种表面蛋白,位于菌体表面,与胞壁的粘肽相结合。它与人及多种哺乳动物血清中的lgG的Fc 段结合,因而可用含SPA的葡萄球菌作为载体,结合特异性抗体,进行协同凝集试验。A蛋白有抗吞噬作用,还有激活补体替代途等活性。SPA是一种单链多肽,与细胞壁肽聚糖呈共价结合,是完全抗原,具属特异性。所有来自人类的菌株均有此抗原,动物源株则少见。
2.多糖抗原具有群特异性,存在于细胞壁,借此可以分群,A群多糖抗原体化学组成为磷壁酸中的N-乙酰葡胺核糖醇残基。B群化学组成是磷壁酸中的N-乙酰区糖胺甘油残基。
3.荚膜抗原几乎所有金黄色葡萄球菌菌株的表面有荚膜多糖抗原的存在。表皮葡萄球菌仅个别是菌株有此抗原。
致病性
致病物质
金葡菌产生多种毒素与酶
1.血浆凝固酶(Coagulase)是能使含有枸椽酸钠或肝素抗凝剂的人或兔血浆发生凝固的酶类物质,致病菌株多能产生,常作为鉴别葡萄球菌有无致病性的重要标志。凝固酶有两种:一种是分泌至菌体外的,称为游离凝固酶(Free coagulase)为蛋白质。作用类似凝血酶原物质,可被人或兔血浆中的协同因子(Cofactor)激活变成凝血酶样物质后,使液态的纤维蛋白原变成固态的纤维蛋白,从而使血浆凝固。另一种凝固酶结合于菌体表面并不释放,称为结合凝固酶(Bound coagulase)或凝聚因子(Chumping factor),在该菌株的表面起纤维蛋白原的特异受体作用,细菌混悬于人或兔血浆中时,纤维蛋白原与菌体受体交联而使细菌凝聚。游离凝固酶采用试管法检测,结合凝固酶则以玻片法测试。凝固酶耐热,粗制品100℃30分钟或高压灭菌后仍保持部分活性,但易被蛋白分解酶破坏。

凝固酶和葡萄球菌的毒力关系密切。凝固酶阳性菌株进入机体后,使血液或血浆中的纤维蛋白沉积于菌体表面,阻碍体内吞噬细胞的吞噬,即使被吞噬后,也不易被杀死。同时,凝固酶集聚在菌体四周,亦能保护病菌不受血清中杀菌物质的作用。葡萄球菌引起的感染易于局限化和形成血栓,与凝固酶的生成有关。
凝固酶具有免疫原性,刺激机体产生的抗体对凝固酶阳性的细菌感染有一定的保护作用。慢性感染患者血清可有凝固酶抗体的存在。
2.葡萄球菌溶血素(Staphylolysin)多数致病性葡萄球菌产生溶血等。按抗原性不同,至少有α、β、γ、δ、ε五种,对人类在致病作用的主要是α溶血素。它是一种“攻击因子”,化学成分为蛋白质,分子量约为30,000,不耐热,65℃30分钟即可破坏。如将α-溶血素注入动物皮内,能引起皮肤坏死,如静脉注射,则导致动物迅速死亡。α溶血素还能使小血管收缩,导致局部缺血和坏死,并能引起平滑肌痉挛。α溶血素是一种外毒素,具有良好的抗原性。经甲醛处理可制成类毒素。
3.杀白细胞素(Leukocidin)含F和S两种蛋白质,能杀死人和兔的多形核粒细胞和巨噬细胞。此毒素有抗原性,不耐热,产生的抗体能阻止葡萄球菌感染的复发。
4.肠毒素(Enterotoxin)从临床分离的金黄色葡萄球菌,约1/3产生肠毒素,按抗原性和等电点等不同,葡萄球菌肠毒素分A、B、C1、C2、C3、D、E和F八个血清型(F这个血清型已经被取消了,因为事实上,F型肠毒素就是TSST1),细菌能产生一型或两型以上的肠毒素,肠毒素是单一的多肽链,含有较多的赖氨酸、酪氨酸、天门冬氨酸和谷氨酸。肠毒素可引起急性胃肠炎即食物中毒。与产毒菌株污染了牛奶、肉类、鱼是虾、蛋类等食品有关,在20℃以上经8~10小时即可产生大量的肠毒素。肠毒素是一种可溶性蛋白质,耐热,经100℃煮沸30分钟不被破坏,也不受胰蛋白酶的影响,故误食污染肠毒素的食物后,在肠道作用于内脂神经受体,传入中枢,刺激呕吐中枢,引起呕吐,并产生急性胃肠炎症状。发病急,病程短,恢复快。一般潜伏期为1~6小时,出现头晕、呕吐、腹泻,发病1~2日可自行恢复,愈后良好。
5.表皮溶解毒素(Epidermolytic toxin)也称表皮剥脱毒素(Exfoliatin)引起人类或新生小鼠的表皮剥脱性病变。主要发生于新生儿和婴幼儿,引导起烫伤样皮肤综合征。主要由噬菌体Ⅱ型金葡萄产生的一种蛋白质,分子量24,000,具有抗原性,可被甲醛脱毒成类毒素。
6.毒性休克综合毒素Ⅰ(Toxic shock syndrome toxin1,TSST1)系噬菌体Ⅰ群金黄色葡萄球菌产生。可引起发热,增加对内毒素的敏感性。增强毛细血管通透性,引起必血管紊乱而导致休克。
7.其他葡萄球菌尚可产生葡激酶(Staphylokinase),亦称葡萄球菌溶纤维蛋白酶(Staphylococcal fibrinolysin),产生耐热核酸酶(Heat-stable nuclease),透明质酸酶(Hyaluronidase),脂酶(Lipase)等。
所致疾病
1.侵袭性疾病主要引起化脓性炎症。葡萄球菌可通过多种途径侵入机体,导致皮肤或器官的多种感染,甚至败血症。
(1)皮肤软组织感染主要有疖、痈、毛囊炎、脓痤疮、甲沟炎、麦粒肿、蜂窝组织炎、伤口化脓等。
(2)内脏器官感染如肺炎、脓胸、中耳炎、脑膜炎、心包炎、心内膜炎等,主要由金葡菌引起。
(3)全身感染如败血症、脓毒血症等,多由金葡菌引起,新生儿或机体防御可能严重受损时表皮葡萄球菌也可引起严重败血症。
2.毒性疾病由金葡菌产生的有关外毒素引起。
(1)食物中毒进食含肠毒素食物后1~6小时即可出现症状,如恶心、呕吐、腹痛、腹泻,大多数病人于数小时至1日内恢复。
(2)烫伤样皮肤综合征多见于新生儿、幼儿和免疫功能低下的成人,开始有红斑,1~2天有皮起皱,继而形成水疱,至表皮脱落。由表皮溶解毒素引起。
(3)毒性休克综合征由TSST1引起,主要表现为高热、低血压、红斑皮疹伴脱屑和休克等,半数以上病人有呕、腹泻、肌痛、结膜及粘膜充血,肝肾功能损害等,偶尔有心脏受累的表现。
(4)假膜炎肠炎本质是一种菌群失调性肠炎,病理特点是肠粘膜被一层炎性假膜所覆盖,该假膜由炎性渗出物、肠粘膜坏死块和细菌组成。人群中约10~15%有少量金葡菌寄居于肠道,当优势菌如脆弱类杆菌、大肠肝菌等因抗菌药物的应用而被抑制或杀灭后,耐药的金葡菌就乘机繁殖而产生毒素,引起以腹泻为主的临床症状。
免疫性
人类对致病性葡萄球菌有一定的天然免疫力。只有当皮肤粘膜受创伤后,或机体免疫力降低时,才易引起感染。患病后所获免疫力不强,难以防止再次感染。
微生物学诊断
不同病型采取不同检材如脓汁、血液、可疑食物、呕吐物及粪便等。
直接涂片镜检
取标本涂片,革兰氏染色后镜检,根据细菌形态,排列和染色性可作出初步诊断。
分离培养
将标本接种于血琼脂平板,甘露醇和高盐培养基中进 行分离培养,孵育后挑选可凝菌落进行涂片、染色、镜检。致病性葡萄球菌的主要特点:凝固酶产生阳性,金黄色素,有溶血性,发酵甘露醇。

食物中毒病人的呕吐物,粪便或剩余食物在作细菌分离鉴定的同时,接种于肉汤培养基中,孵育后取滤液注射于6~8周龄的幼猫腹腔,注射后4小时内发生呕吐、腹泻、体温升高或死亡提示有肠毒素存在的可能。
防治原则
加强卫生宣传教育,讲究个人卫生,注意防护措施。皮肤创伤应及时处理,注意中西医结合,合理用药,避免滥用抗生素。
研究发现
2021年12月14日,来自新加坡国立大学医院和国家传染病中心的研究团队发现一种新葡萄球菌,并以新加坡命名。名为新加坡葡萄球菌(Staphylococcus singaporensis)的细菌,属于金黄色葡萄球菌(Staphylococcus aureus)的其中一类。金黄色葡萄球菌是一种常见的病原体,可造成包括皮肤和伤口感染、手术部位感染至血管感染,甚至致命。
治疗方法
1.一般治疗 及时诊断,及早应用适宜的抗菌药物,为治疗严重葡萄球菌感染获得成功的主要关键。除抗菌药物外,还应重视提高人体免疫功能,纠正水、电解质紊乱,抢救感染性休克和保护心、肺、肾、肝等重要脏器功能等综合措施。肾上腺皮质激素是否采用,必须充分权衡其利弊后而决定,除非有严重毒血症,并与有效抗菌药物合用,一般以不用为妥。人血丙种球蛋白(丙种球蛋白)适用于低球蛋白血症等抗体缺陷性疾病患者。
2.外科处理 脓液的充分引流,常是处理某些伴有脓肿的葡萄球菌感染的先决条件。疖、甲沟炎、睑腺炎等表浅感染,在自行穿破或切开排脓后即迅速痊愈,一般无需抗菌药物。皮下深部脓肿或骨髓炎有脓肿形成时则须切开引流,肺脓肿可采取体位引流,这些感染均须加用抗菌药物治疗。多房性肝脓肿主要依靠药物治疗,单房较大脓肿则在内科药物治疗效果不满意时,考虑外科引流。人工心脏瓣膜或静脉插管伴有葡萄球菌感染时,必须更换瓣膜或拔除插管,单用抗菌药物常不能控制感染。急性金葡菌心内膜炎的内科治疗疗效不佳,反复出现栓塞或发生急性心力衰竭者均为手术指征。
3.抗菌治疗 葡萄球菌感染患者有全身症状或局部病灶呈迅速发展的趋势时,应立即采用积极的抗菌治疗。